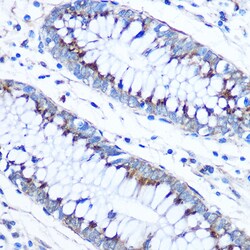
Invitrogen FAM3D Polyclonal Antibody 100 &mu;L; Unconjugated:Antibodies,

missing translation for 'onlineSavingsMsg'
Learn More
Learn More
Invitrogen™ FAM3D Polyclonal Antibody


Rabbit Polyclonal Antibody
Brand: Invitrogen™ PA5109709
This item is not returnable.
View return policy
Description
Immunogen sequence: RSYMSFSMKT IRLPRWLAAS PTKEIQVKKY KCGLIKPCPA NYFAFKICSG AANVVGPTMC FEDRMIMSPV KNNVGRGLNI ALVNGTTGAV LGQKAFDMYS GDVMHLVKFL KEIPGGALVL VASYDDPGTK MNDESRKLFS DLGSSYAKQL GFRDSWVFIG AKDLRGKSPF EQFLKNSPDT N.
FAM3D (FAM3 Metabolism Regulating Signaling Molecule D) is a Protein Coding gene. Diseases associated with FAM3D include Deafness, Autosomal Recessive 17 and Scheuermann Disease. Gene Ontology (GO) annotations related to this gene include cytokine activity. An important paralog of this gene is FAM3C. [GeneCards].
Specifications
| FAM3D | |
| Polyclonal | |
| Unconjugated | |
| Fam3d | |
| 2310076N21Rik; AV067083; cytokine-like protein EF-7; EF7; EF-7; Fam3d; family with sequence similarity 3 member D; family with sequence similarity 3, member D; Oit1; oncoprotein induced transcript 1; oncoprotein induced transcript 1 homolog; oncoprotein-induced protein 1; Protein EF-7; protein FAM3D; UNQ567/PRO1130 | |
| Rabbit | |
| Affinity Chromatography | |
| RUO | |
| 131177, 18300, 289949 | |
| -20°C, Avoid Freeze/Thaw Cycles | |
| Liquid |
| ELISA, Immunohistochemistry (Paraffin), Western Blot, Immunocytochemistry | |
| 1.11 mg/mL | |
| PBS with 50% glycerol and 0.01% thimerosal; pH 7.3 | |
| P97805, Q96BQ1 | |
| Fam3d, Oit1 | |
| Recombinant protein (or fragment). | |
| 100 μL | |
| Primary | |
| Human, Mouse, Rat | |
| Antibody | |
| IgG |
Product Content Correction
Your input is important to us. Please complete this form to provide feedback related to the content on this product.
Product Title
Spot an opportunity for improvement?Share a Content Correction